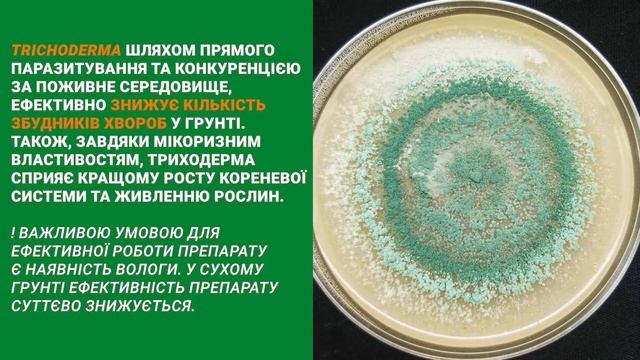
Грунтовий інсекто-фунгіцид - MetaRiz смотреть онлайн

Л
Лесные сокровища
Смотреть все онлайн видео автора канала
 00:50
00:50
Картошка с беконом на мангале
 00:24
00:24
Foo baker house VOL.1
 01:33
01:33
Сломанный #гриб трутовик. Месяц спустя
 13:58
13:58
Бомбит от дрифта езжу на летней ризине
 44:59
44:59
Superficial Mycoses
 01:41
01:41
Презентационный ролик о компании
 00:14
00:14
БЕЛЫЙ ГРИБ🐿🦔МОЖЖЕВЕЛОВЫЙ!!! 🍄 #shorts
 00:24
00:24
Грибы - Тает Лед. Пародия. Ауыл жастары!
 00:13
00:13
Веселка
 00:55
00:55
Вишни. стихи Максима Фоменко
 15:16
15:16
B.Sc.Part I,Botany Syllabus, By Dr.Ajay Sharma,Asso. Prof. Botany,Government Bangur College,Didwana
 01:48
01:48
HOFMANNITA - Водный (speed up)
 07:20
07:20
Веселка. 1 клас.
 00:37
00:37
Как плести мухоморы, есть подробное видео в моем профиле. #плетеныймухомор #мухомор
 42:55
42:55
Infectious Disease Control in a High Quality, High Volume Spay Neuter Setting - conference recordin
 05:13
05:13
Дружба народов 29 10 16 Гэлжамал + Увишневом саду
 17:49
17:49
THE LAST OF US: PART I #007 - U-Bahn Terror ᴳᴱᴿᴹᴬᴺ ⁴ᴷ
 13:46
13:46
July Virtual Mushroom ID Table (MAWDC July 2021)
 02:31
02:31
Victory Sour Monkey
 04:45
04:45
Beef tagliata
 02:30
02:30
Как мы снимали «А знаете ли вы, что?». Улыбки, помидоры и природный газ
02:27
02:27
Грунтовий інсекто-фунгіцид - MetaRiz
 00:31
00:31
karmy dla kotów Princess Premium Nature Power 100% zdrowego mięsa
 02:40
02:40
поездка за грибами, слишком много опят!!! #грибы #гриб #поездка
Страница 1
Вперед →
Рады Вас приветствовать на ruvideo.click, только у нас в кинотеатре у вас есть возможность сделать выбор из огромного количества и посмотреть интересующие онлайн фильмы. Без регистрации, онлайн и при чем совершенно бесплатно вы здесь можете смотреть любой фильм или видео, без отправки смс сообщений и пустой траты денег, все что необходимо это включить и получать удовольствие от просмотра. Лучшего качества видео вы просто не найдете. У нас база видео контента обновляется ежедневно, и это касается не только фильмов, но и сериалов и телепередач. Мировые премьеры как отечественного так и зарубежного кинематографа появляются на сайте одновременно с выходом в прокат. Доброго времени суток и приятного всем просмотра!
Лучше чем онлайн кинотеатр ULTRADOX!